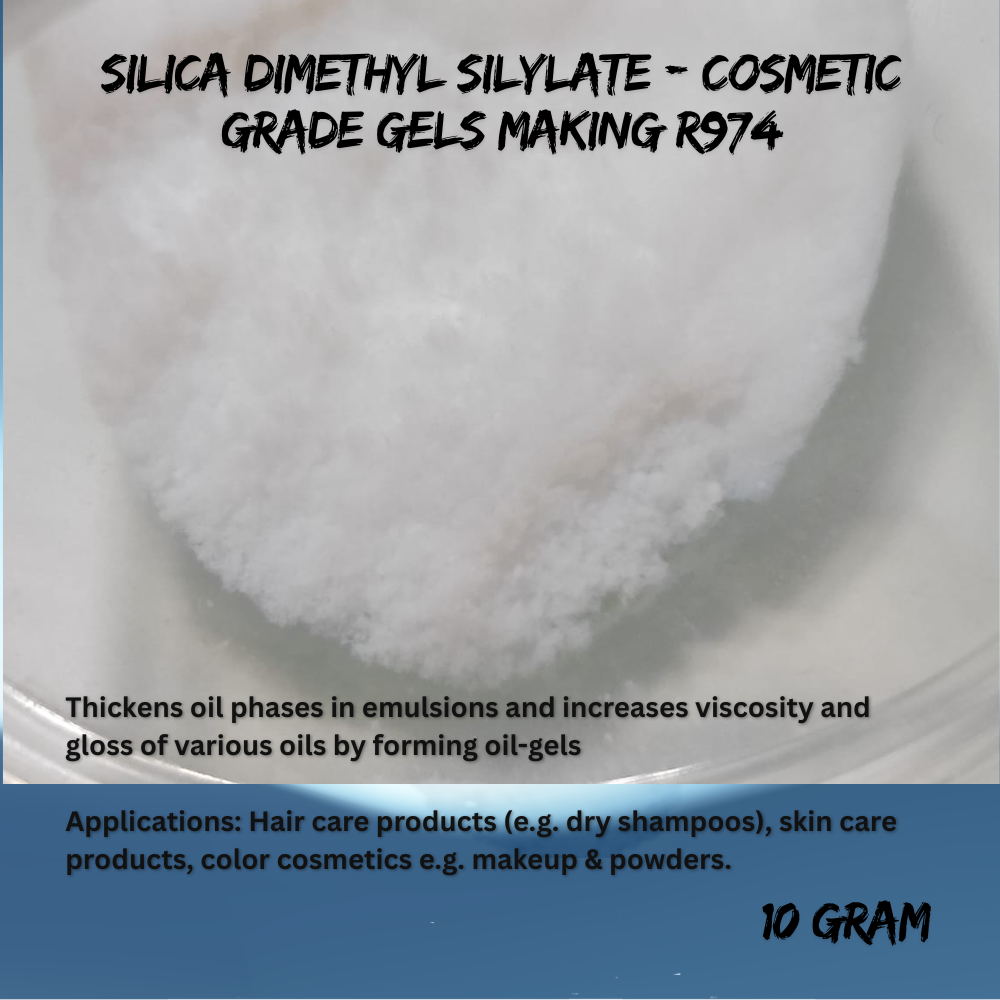

Silica Dimethyl Silylate R974 is a premium cosmetic-grade hydrophobic silica powder widely used in gel formulations, creams, lotions, and cosmetic products to enhance texture, improve stability, and create a smooth velvet touch.
It acts as a powerful rheology modifier and oil-control agent, reducing greasiness while improving suspension of active ingredients. Ideal for professional cosmetic manufacturers, gel formulators, and perfume gel production.
Silica Dimethyl Silylate R974 هو مسحوق سيليكا تجميلي احترافي يستخدم على نطاق واسع في صناعة الجل، الكريمات، اللوشن، والمستحضرات التجميلية لتحسين القوام وزيادة ثبات التركيبة ومنح ملمس مخملي فاخر.
يساعد على تقليل اللمعان الدهني وتحسين توزيع المواد الفعالة داخل المنتج، ويستخدم بكثرة في جلات العطور وجل الشعر ومستحضرات العناية بالبشرة.

Reviews
There are no reviews yet.